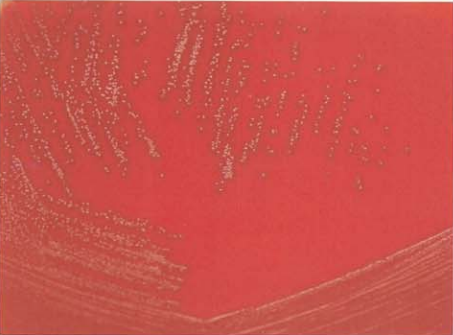
图 2肠膜无色藻菌在血琼脂平板上的菌落特征(18~24h)

肠膜无色藻菌、戊糖片球菌、肯茨创伤球菌及黏液罗氏菌的形态与生化反应
来源:武汉市灰藻生物科技有限公司 浏览量:272 发布时间:2026-01-30 16:57:45
引言
无色藻菌属(Leuconostoc),也称明串珠菌属或四联球菌属,包括:肉无色藻菌(L. citreum)、乳酸无色藻菌(L. lactis)、柠檬无色藻菌(L. citreum)、肠膜无色藻菌(L. mesenteroides)、酸败气无色藻菌(L. gasicomitatum)、果糖无色藻菌(L. fructosum)、无花果无色藻菌(L. ficulneum)、假肠膜无色藻菌(L. pseudomesenteroides)和冷生无色藻菌(L. gelidum)等。代表菌种为肠膜无色藻菌。
肠膜无色藻菌 L. mesenteroides
(一)肠膜无色藻菌形态与染色
革兰阳性球菌,菌体大小为(0.5~0.7)μm×(0.7~1.2)μm,呈卵圆形、球形、扁豆状等,成对、链状排列,肉汤培养液涂片染色呈杆状,无芽胞,无鞭毛(图 1)。

图 1肠膜无色藻菌纯培养的镜下形态
(二)肠膜无色藻菌培养特征
在血琼脂平板上35℃培养18~24 h,形成光滑、圆形、灰白色的细小菌落,α溶血或不溶血(图 2),与草绿色链球菌相似,极少数菌株有β溶血环。在液体肉汤培养基中浑浊生长,有沉淀现象。兼性厌氧菌,营养要求高,生长缓慢。
图 2肠膜无色藻菌在血琼脂平板上的菌落特征(18~24h)
(三)肠膜无色藻菌生化特征
触酶试验阴性,对万古霉素耐药,主要生化反应见表 1。
| 试验 | 结果 | 试验 | 结果 |
|---|---|---|---|
| 氧化酶 | - | 硝酸盐 | - |
| 葡萄糖 | + | 脲酶 | - |
| 乳糖 | + | 吲哚 | - |
| 麦芽糖 | + | PYR | - |
| 七叶苷 | + | 精氨酸双水解酶 | - |
| 6.5% NaCl生长 | + | 明胶 | - |
注:+,90%以上菌株阳性;-,90%以上菌株阴性;PYR,吡咯烷酮芳基酰胺酶
(四)肠膜无色藻菌鉴别要点
- 本菌特征
- 与片球菌的区别
- 与无色藻菌属内其他菌种的鉴别
| 菌名 | 6.5% NaCl生长 | ONPG | 七叶苷 | 阿拉伯糖 | 纤维二糖 | 葡萄糖 | 葡萄糖酸盐 | 乳糖 | 麦芽糖 | 甘露醇 | 蜜二糖 | 棉子糖 | 水杨苷 | 蔗糖 | 木糖 |
|---|---|---|---|---|---|---|---|---|---|---|---|---|---|---|---|
| 乳酸无色藻菌 | + | + | -/+ | -/+ | - | + | - | + | + | - | +/- | +/- | - | + | - |
| 柠檬无色藻菌 | d | ND | + | + | + | + | + | + | - | + | V | - | - | + | +/- |
| 假肠膜无色藻菌 | + | ND | + | -/+ | + | + | V | V | + | -/+ | -/+ | V | +/- | + | + |
| 谲诈无色藻菌 | + | ND | - | - | - | + | ND | - | + | W | - | - | ND | + | - |
| 肠膜无色藻菌 | |||||||||||||||
| 肠膜亚种 | d | + | -/+ | -/+ | +/- | + | + | V | + | W | + | +/- | + | + | + |
| 葡聚糖亚种 | + | - | +/- | - | V | + | + | + | + | V | V | V | + | + | V |
| 乳酸亚种 | + | - | + | - | - | + | - | + | V | -/+ | - | -/+ | - | V | -/+ |
注:+,90%以上菌株阳性;-,90%以上菌株阴性;+/-,多数阳性,少数阴性;-/+,多数阴性,少数阳性;W,迟缓反应;d,不同反应;V,结果可变;ND,无资料
(五)肠膜无色藻菌药敏试验的药物种类选择
药敏试验的药物种类选择见表 3。
| 抗菌药物名称 | |
|---|---|
| 可选药物 | 青霉素或氨苄西林、米诺环素、氯霉素 |
| 天然耐药 | 万古霉素、替考拉宁 |
注:上述药敏试验所选药物仅有MIC判读折点,具体参照CLSI M45-A3文件
(六)肠膜无色藻菌结果解释与要点提示
无色藻菌广泛分布在植物和食物中,也存在于人胃肠道中,是一种条件致病菌,可引起肺炎、脑膜炎、心内膜炎、骨髓炎、尿路感染、脑脓肿、眼内膜炎等多种疾病。
从无菌部位如血液、深部组织等分离出的无色藻菌应进行药敏试验,严重感染如感染性心内膜炎,需青霉素类联合氨基糖苷类治疗。
二、片球菌属(Pediococcus)
包括乳酸片球菌(P. acidilactici)、小片球菌(P. parvulus)、有害片球菌(P. damnosus)、戊糖片球菌(P. pentosaceus)、糊精片球菌(P. dextrinicus)、意外片球菌(P. inopinatus)等,原马尿片球菌(P. urinaeequi)现已划归气球菌属,嗜盐片球菌(P. halophilus)现已划归至四联球菌属(Tetragenococcus)。代表菌种为戊糖片球菌。
戊糖片球菌 P. pentosaceus
(一)戊糖片球菌形态与染色
革兰阳性球菌,直径1.2~2.0 μm,单个、成双或成堆排列,无芽胞,无荚膜,无鞭毛(图 3)。

图 3戊糖片球菌纯培养的镜下形态(革兰染色)
(二)戊糖片球菌培养特性
在血琼脂平板上35℃培养18~24 h后,形成较小、灰色、不透明、α溶血菌落(草绿色样,见图 4),48 h之后逐渐增大。片球菌营养要求高,如有害片球菌需要半胱氨酸。有害片球菌、意外片球菌、小片球菌生长缓慢,2~5日才可生长出菌落。

图 4戊糖片球菌在血琼脂平板上的菌落特征(18~24h)
(三)戊糖片球菌生化特性
氧化酶阴性,触酶阴性,对万古霉素耐药,主要生化反应见表 4。
| 试验 | 结果 | 试验 | 结果 |
|---|---|---|---|
| 6.5% NaCl生长 | + | 核糖 | + |
| 精氨酸双水解酶 | + | 木糖 | d |
| 乳糖 | d | 松三糖 | - |
| 蔗糖 | - | 海藻糖 | + |
| 阿拉伯糖 | + | 糊精 | - |
注:+,90%以上菌株阳性;-,90%以上菌株阴性;d,11%~89%菌株阳性
(四)戊糖片球菌鉴别要点
- 本菌特征
- 与粪肠球菌的鉴别
- 片球菌属内菌种鉴定与鉴别
| 菌名 | 40℃生长 | 6.5% NaCl生长 | 精氨酸双水解酶 | 乳糖 | 蔗糖 | 阿拉伯糖 | 核糖 | 木糖 | 松三糖 | 海藻糖 | 糊精 | 淀粉 |
|---|---|---|---|---|---|---|---|---|---|---|---|---|
| 戊糖片球菌 | + | + | + | d | - | + | + | d | - | + | - | - |
| 乳酸片球菌 | + | + | + | d | - | d | + | + | - | d | - | - |
| 有害片球菌 | - | - | - | - | d | - | - | - | d | + | - | - |
| 糊精片球菌 | + | - | - | d | d | - | - | - | - | + | - | + |
| 意外片球菌 | - | d | - | + | d | - | - | - | - | + | d | - |
| 小片球菌 | - | + | - | - | - | - | - | - | - | d | - | - |
注:+,90%以上菌株阳性;-,90%以上菌株阴性;d,11%~89%菌株阳性
(五)戊糖片球菌药敏试验的药物种类选择
戊糖片球菌药敏试验的药物种类选择见表 6。
| 抗菌药物名称 | |
|---|---|
| 可选药物 | 青霉素、氨苄西林、氯霉素、亚胺培南 |
| 天然耐药 | 万古霉素、替考拉宁 |
注:上述药敏试验所选药物仅有MIC判读折点,具体参照CLSI M45-A3文件
(六)戊糖片球菌结果解释与要点提示
片球菌属是乳酸菌,普遍存在于发酵的蔬菜、乳制品、肉类等食品中。乳酸片球菌、戊糖片球菌是机会致病菌,可引起人类肝脓肿、菌血症、肺炎、肠炎、心内膜炎、腹膜炎、腹泻和尿路感染等疾病。
从无菌体液如血液、胸腔积液、腹水、深部组织等分离出的分离株应进行药敏试验,严重感染如感染性心内膜炎,需青霉素类联合氨基糖苷类治疗。
三、创伤球菌属
创伤球菌属是1993年命名的一个新菌属。因大部分菌株是从创伤分泌物中分离的,故以创伤球菌命名。属内包括肯茨创伤球菌(H. kunzii)和Helcococcus sueciensis(2004年从人类标本中新分离出的)。
肯茨创伤球菌 H. kunzii
(一)肯茨创伤球菌形态与染色
革兰阳性球菌(图 5)。

图 5 肯茨创伤球菌纯培养的镜下形态(革兰染色)
(二)肯茨创伤球菌培养特性
兼性厌氧菌,生长慢,初次分离需要在5%~10% CO₂环境中。在含有血清或吐温80血琼脂平板上35℃培养18~24 h,形成细小、圆形、凸起、浅灰白色的菌落(图 6)。往往与其他细菌共生。

图 6 肯茨创伤球菌在血琼脂平板上的菌落特征(18~24h)
(三)肯茨创伤球菌生化反应
触酶试验阴性,主要生化反应见表 7。
| 试验 | 结果 | 试验 | 结果 |
|---|---|---|---|
| 葡萄糖 | + | 6.5% NaCl生长 | + |
| 乳糖 | + | PYR | + |
| 阿拉伯糖 | - | LAP | - |
| 棉子糖 | - | 明胶 | - |
| 核糖 | - | 脲酶 | - |
| 山梨醇 | - | VP | - |
| 七叶苷 | + | 万古霉素 | S |
注:+,90%以上菌株阳性;-,90%以上菌株阴性;S,敏感。PYR,吡咯烷酮芳基酰胺酶;LAP,亮氨酸氨基肽酶
(四)肯茨创伤球菌鉴别要点
- 本菌特征
- 与绿色气球菌属的鉴别
| 鉴别特性 | 肯茨创伤球菌 | 绿色气球菌 |
|---|---|---|
| 6.5% NaCl生长 | V | + |
| 胆汁七叶苷 | - | + |
| ONPG | - | + |
| 蔗糖 | - | + |
| 甘露醇 | - | V |
注:+,90%以上菌株阳性;-,90%以上菌株阴性;V,反应不定
- 与其他革兰阳性球菌的鉴别
| 菌名 | PYR | LAP | BGUR | 6.5% NaCl生长 | 40%胆盐生长 | 精氨酸双水解酶 | 卫星现象 | 万古霉素 |
|---|---|---|---|---|---|---|---|---|
| 创伤球菌 | + | - | ND | + | - | ND | - | S |
| 缺陷乏养菌 | + | + | - | - | - | - | + | S |
| 溶血孪生球菌 | + | + | ND | - | - | ND | - | S |
| 毗邻颗粒链菌 | + | + | - | - | - | - | + | S |
| 苛养颗粒链菌 | + | + | - | - | - | + | + | S |
| 绿色气球菌 | + | - | ND | + | V | ND | - | S |
| 格鲁比卡球菌 | + | - | ND | + | V | ND | - | S |
注:+,90%以上菌株阳性;-,90%以上菌株阴性;V,11%~89%菌株阳性;ND,无资料;S,敏感。BGUR,β半乳糖苷酶;LAP,亮氨酸氨基肽酶;PYR,吡咯烷酮芳基酰胺酶
(五)肯茨创伤球菌药敏试验的药物种类选择
目前还没有相应的测定方法和解释标准。
(六)肯茨创伤球菌结果解释与要点提示
肯茨创伤球菌是一种机会致病菌,是人类和动物皮肤的常住菌群。可以从混合感染的外伤标本中分离到。少数创伤球菌会对青霉素和克林霉素敏感,大多数创伤球菌对红霉素耐药。
四、罗氏菌属
罗氏菌属有6个种,其中黏液罗氏菌(R. mucilaginosa,原来被称为黏滑口腔球菌)、龋齿罗氏菌(R. dentocariosa)和R. aeria被认为是与临床相关的。
黏液罗氏菌 R. mucilaginosa
(一)黏液罗氏菌形态与染色
革兰阳性球菌,多成双、四联状、葡萄状排列,菌体较葡萄球菌大,镜下立体感较强(图 7),有囊状感,有荚膜。

图 7黏液罗氏菌纯培养的镜下形态(革兰染色)
(二)黏液罗氏菌培养特性
在血琼脂平板上35℃培养18~24 h,形成光滑、圆形凸起、边缘整齐、树胶样、不溶血、灰白色菌落(图 8)。在麦康凯琼脂平板上不生长。

图 8黏液罗氏菌在血琼脂平板上的菌落特征(18~24h)
(三)黏液罗氏菌生化反应
触酶试验阴性,主要生化反应见表 10。
| 试验 | 结果 | 试验 | 结果 |
|---|---|---|---|
| 触酶 | - | 葡萄糖 | + |
| 氧化酶 | - | 麦芽糖 | + |
| 葡萄糖O/F | F | 蔗糖 | + |
| 硝酸盐 | + | 甘露醇 | V |
| VP | + | 水杨苷 | + |
| 七叶苷 | + | 果糖 | + |
注:+,90%以上菌株阳性;-,90%以上菌株阴性;V,不定;O/F,氧化/发酵
(四)黏液罗氏菌鉴别要点
- 本菌特征
- 与龋齿罗氏菌的鉴别
| 菌名 | 触酶 | O/F | 硝酸盐 | 七叶苷 | 葡萄糖 | 麦芽糖 | 蔗糖 | 甘露醇 |
|---|---|---|---|---|---|---|---|---|
| 黏液罗氏菌 | - | F | + | + | + | + | + | V |
| 龋齿罗氏菌 | V | F | + | + | + | + | + | - |
注:+,90%以上菌株阳性;-,90%以上菌株阴性;V,不定;F,发酵
- 与藤黄微球菌的鉴别
- 与葡萄球菌的鉴别
(五)药敏试验的药物种类选择
药敏试验的药物种类选择见表 12。
| 抗菌药物名称 | |
|---|---|
| 可选药物 | 青霉素、万古霉素、红霉素、克林霉素、左氧氟沙星、复方磺胺甲噁唑 |
注:上述药敏试验所选药物仅有MIC判读折点,具体参照CLSI M45-A3文件
(六)黏液罗氏菌结果解释与要点提示
黏液罗氏菌由Migula于1900年首次报道,当时称黏液微球菌(M. mucilaginosa)。1907年由Andrewes和Gordon再次命名为唾液葡萄球菌(S. salivarius),1967年,Gordon基于其厌氧发酵葡萄糖的能力而进一步加以证实。1970年Bergan等提议将其再次命名为黏液微球菌。1982年由Bergan和Kocur根据其与微球菌和葡萄球菌生化特性的不同,将其另立为口腔球菌属,2000年《临床微生物手册》(第八版)将其作为罗氏菌属中的一个种,命名为黏滑罗氏菌。
黏液罗氏菌是存在于口腔中的正常菌群,也是一种机会致病菌,但对于来自无菌部位标本如血液、深部组织、植入假体装置的分离株,通常认为是致病菌。早在1994年Ben Salah H等报道了一例2岁血液病患者从脑脊液中检出此菌,诊断为黏液罗氏菌性脑膜炎;2002年Perez-Vega C等报道了一例脑动脉瘤患者,由于二尖瓣韧带脱垂,黏液罗氏菌引起的心内膜炎;Bureau Chalot F等在2003年报道了一例免疫力低下患者椎间盘术后感染此菌;Gmson D等报道了一例24岁女性患者,白血病化疗后出现肺炎,肺泡灌洗液没有培养出黏液罗氏菌,但从患者血液中两次检出此菌。随着引起感染的报道不断增加,临床检验人员在遇到镜下形态为成双、四联状排列的阳性球菌,不要认为是微球菌或污染菌,还应怀疑黏液罗氏菌的可能。
对杆菌肽、呋喃唑酮、新生霉素均敏感,对溶菌素和多黏菌素B耐药。ATB ID32-STAPH试条和BBL Crystal(Becton Dickinson)可准确鉴定黏液罗氏菌。
参考文献
周庭银, 章强强 主编. 临床微生物学诊断与图解(第4版)[M]. 上海: 上海科学技术出版社, 2019.
相关产品
HZB224072:肠膜明串珠菌 | Leuconostoc mesenteroides
HZB222557:戊糖片球菌 | Pediococcus pentosaceus
HZB517322:黏液罗斯氏菌 | Rothia mucilaginosa
敬请关注灰藻生物,共筑健康未来!
— 武汉市灰藻生物科技有限公司团队敬上
灰藻生物:我们期待着与客户共同成长,共创生命科学的美好未来!
更新日期:2026-01-30
编制人:木木
审稿人:小藻